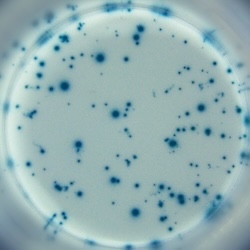

IFN-y specific spots produced by 2.5x10E4 rat (Wistar) splenocytes.
Stimulation: PMA/ionomycin
Stimulation: PMA/ionomycin
Catalogue Number
CT079-B2
Description
Rat IFN-γ T cell ELISPOT kit - 2-plate
Price
€ 485.00
staining
Enzymatic
Characteristics
PVDF
Contents
- coating antibody
- biotinylated detection antibody
- Streptavidin-HRP
- TMB substrate
- Blocking stock solution
- Dilution buffer
- Tween-20
- PVDF ELISPOT plates with lids and cover slips
- manual
References list
- Immune response induced in rodents by anti-CoVid19 plasmid DNA vaccine via pyro-drive jet injector inoculation.
- Inhibition of collagen-induced arthritis by DNA vaccines encoding TCR Vbeta5.2 and TCR Vbeta8.2.
- Mucosal and systemic immunization with targeted fusion anti-caries DNA plasmid in young rats.
- Modulation of NKT cells and Th1/Th2 imbalance after alpha-GalCer treatment in progressive load-trained rats.



